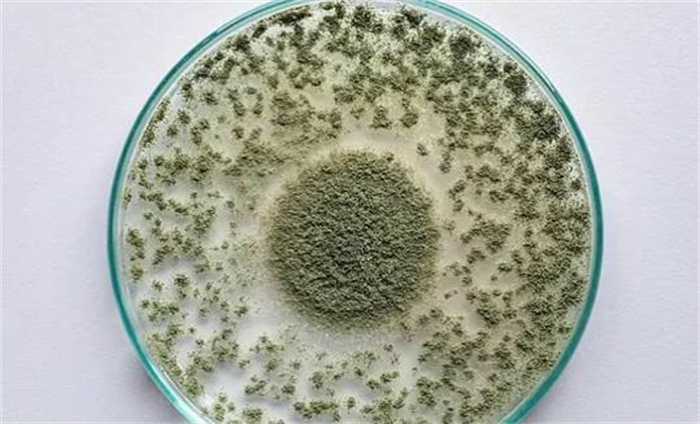

美国考古学家在进入到一个古埃及的墓穴之后,出现了咳血的症状
当我们说到古埃及木乃伊的时候,一定会想到木乃伊的诅咒,木乃伊这种买账的方式是很多人都知道的,不过大家对于他的印象都是恐怖和神秘。在很多的影视作品当中也都有着木乃伊的诅咒,当然了,现实生活当中大多数人都认为木乃伊只是一种丧葬形式而已,根本不存在所谓的诅咒,可是美国一个考古学家却几乎认定了这一点。

古埃及考古
美国考古学家罗曼尼在前段时间说,自己曾在2019年的时候为了拍摄一个和木乃伊有关的节目,就进入到了一座古埃及的古墓,在其中并没有走得太远,也没有经历太长的时间,在当时他并没有发现什么恐怖的东西,可是在之后的一段时间居然出现了咳血的症状,还出现了一些幻觉,到了医院,医生给他注射了一些抗生素,经过了几天时间的休息,才终于康复。

木乃伊的诅咒
罗曼尼说医生觉得他之所以会得病,是因为在古墓里面有灰尘或者是细菌等等,才会让他的身体出现这种变化,而罗曼尼则是表示他当时科学的时候认为自己已经接近了死亡,感觉那个古墓里面好像有什么东西缠绕着他一样,有着超自然的诅咒,不过还好,在这之后他就没有过任何不舒服的感觉,所以可以断定木乃伊的诅咒现在来看还是不存在的。当然我们不能够否认世界上是否会有着超自然现象的出现。
曲霉菌入侵
根据罗曼尼自己描述的病症我们可以认定罗曼尼所得的病就是曲霉菌入侵到人体所引发的曲霉病,主要会影响到一个人的肺部,要是及时治疗还好,要是治疗的比较晚,可能就会有生命危险,到了那个时候就是真的诅咒了。